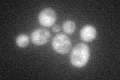
YGR123C
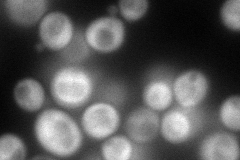
YGR123C
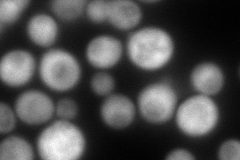
YGR123C
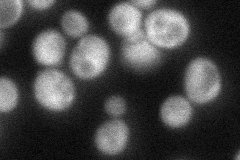
YGR123C
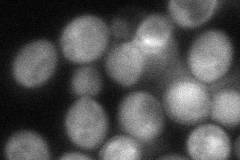
YGR123C

View description
Protein serine/threonine phosphatase with similarity to human phosphatase PP5; present in both the nucleus and cytoplasm; expressed during logarithmic growth; computational analyses suggest roles in phosphate metabolism and rRNA processing
Localization:
Intensity:
Fold change:
Significance:
-
C’ GFP library in SD
cytosol57.13 -
N' NOP1pr-GFP in SD
cytosol,punctate155.076 -
N' TEF2pr-mCherry in SD
cytosol204.754 -
N' NATIVEpr-GFP in SD
cytosol58.5172 -
N' TEF2pr-VC and Cyto-VN in SD
cytosol70.2657 -
C’ GFP library in SD+DTT

cytosol54.110.94No -
C’ GFP library in SD+H2O2

cytosol54.290.95No -
C’ GFP library in Starvation Media

nucleusN/AN/AYes -
C’ GFP library on the background of Pup2-DaMP

cytosol -
C’ GFP library on the background of CCT mutant

cytosol61.24621.07199No
